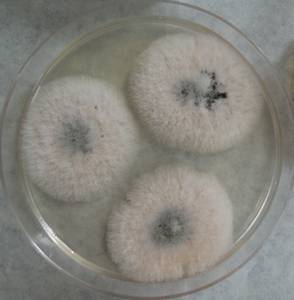
MSU_FS-03358_01, Район Манг Занг (Mang Yang districts), Провинция Зялай (Gia Lai province) (Вьетнам)

Всего записей: 5
Всего страниц: 1
По организмам

- ID образца
- 0000002675678
- Вид
- Clonostachys rosea
- Штамм
- F-426
- Место сбора
- Карачаевский район, Карачаево-Черкесская Республика (Россия)
- Топоним
- Малая Хатипара

- ID образца
- 0000001179970
- Вид
- Clonostachys rosea
- Штамм
- F-230
- Место сбора
- Мурманская область (Россия)
- Топоним
- Беломорская Биологическая Станция МГУ

- ID образца
- 0000002675490
- Вид
- Clonostachys rosea
- Штамм
- F-97

- ID образца
- 0000001189898
- Вид
- Clonostachys rosea
- Штамм
- MSU_FS-03359
- Место сбора
- Район Манг Занг (Mang Yang districts), Провинция Зялай (Gia Lai province) (Вьетнам)
- Топоним
- Адзун (A Yun commune)
- ID образца
- 0000001189896
- Вид
- Clonostachys rosea
- Штамм
- MSU_FS-03358
- Место сбора
- Район Манг Занг (Mang Yang districts), Провинция Зялай (Gia Lai province) (Вьетнам)
- Топоним
- Адзун (A Yun commune)